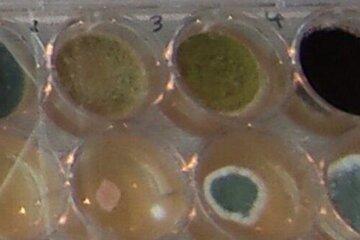

Les champignons filamenteux, saurez-vous les…
Biodiversité : les champignons filamenteux, les observer et les comprendre

Découvrez le monde de la recherche à travers des ateliers et comprenez l'apport de la science grâce à des conférences.
Conférence du Prof. Patrick Dufour, cancérologue, vice-président du Comité du Bas-Rhin de la Ligue contre le cancer
Santé et intelligence artificielle IA, un nouvel outil au service des patients : bénéfices et dérives
Vendredi 3 octobre : 20h00 - Maison des Arts de Lingolsheim
Conférence du Prof. Jean-Christophe Cassel, Professeur à l'Université de Strasbourg et au Laboratoire de neurosciences cognitives et adaptatives (LNCA)
Comment les neurones construisent nos souvenirs
Samedi 4 octobre : 20h00 - Maison des Arts de Lingolsheim
Découvrez le monde fascinant de la recherche à travers des ateliers: samedi 4 et dimanche 5 octobre de 14h00 à 17h00 Gymnase Im Sand (Collège Maxime Alexandre) - vendredi 3 oct scolaires uniquement (sur réservation):
Environnement: le monde des abeilles et de l'apithérapie
Santé : Mitochondries et maladies génétiques rares
Le monde de l'ARN et des aptamères: réalité virtuelle
Plantes: Chrorophylle et resistance aux maladies
Santé : l'Intestin notre 2ième cerveau
Neurosciences : comprendre et observer le fonctionnement de notre cerveau
Biodiversité : les champignons filamenteux, les observer et les comprendre
Chimie et Physique : faire des expériences
Sciences de l'ingénieur: Des inventrices, ça existe !
Santé: la levure de boulanger au laboratoire
Comité du Bas-Rhin de La Ligue contre le cancer (Ligue 67): prévention et traitement
Sciences participatives : avec le jeu Mendeleieva, découvrez les éléments chimiques de votre vie de tous les jours et des femmes scientifiques étudiant ces éléments.
Ingéniérie et Physique: la photonique dans la vie de tous les jours
Géographie et société: Où sont les femmes dans votre ville ?
Sciences au féminin: Exposition XXElles